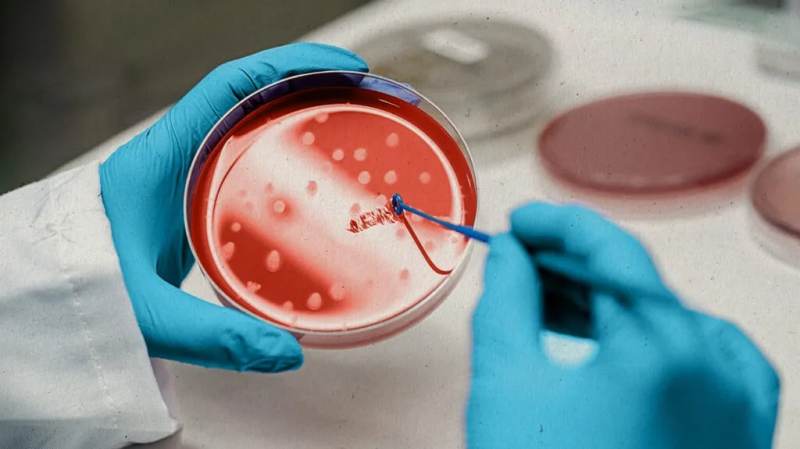
UP First Stem Cell Research unit in Kanpur for cancer patients

UP First Stem Cell Research unit in Kanpur for cancer patients
प्रदेश के कानपु में अब न सिर्फ कैंसर समेत लाइलाज बीमारियों का इलाज होगा, बल्कि इस पर रिसर्च भी हो सकेंगे। इसके लिए यूपी की पहली स्टेम सेल रिसर्च यूनिट कानपुर में बनाई जाएगी। इसका निर्माण जीएसवीएम मेडिकल कॉलेज में होगा। आईसीएमआर की नेशनल एपेक्स कमेटी ने मंजूरी दे दी है। मेडिकल कॉलेज से भावी प्रोजेक्ट का ब्लूप्रिंट मांगा गया है। डॉक्टरों ने कोरोना की रफ्तार सुस्त पड़ने के बाद स्टेम सेल रिसर्च यूनिट के लिए आईसीएमआर के सामने प्रस्ताव रखा था। इसके बाद नेशनल एपेक्स कमेटी फॉर स्टेम सेल रिसर्च एंड थेरेपी के सामने रखा गया। कमेटी ने मेडिकल कॉलेज के ट्रांस फ्यूजन मेडिसिन की हेड प्रो.लुबना खान से बिन्दुवार रिपोर्ट मांगी। आईसीएमआर ने यूनिट के लिए रजिस्ट्रेशन कर दिया है। स्टेम सेल कल्चर लैब को भी हरी झंडी मिल गई है ताकि स्टेम सेल ग्रो करने के बाद मरीजों को फायदा मिल सके। हैलट में बने ब्लड बैंक की ऊपरी मंजिल पर यूनिट के निर्माण का प्रोजेक्ट तैयार कर शासन को भेज दिया गया है। इस पर कुल 20 करोड़ रुपये ख्र्च होंगे। 13 करोड़ से निर्माण और सात करोड़ से उपकरण आएंगे।
इन बीमारियों का होगा इलाज
विशेषज्ञों के अनुसार स्टेम सेल थेरेपी से डिमेंशिया, ऑटिज्म, मल्टीपल स्क्लेरोसिस, सेरेब्रल पाल्सी और मस्कुलर डिस्ट्रॉफी बीमारियों का इलाज होगा। इससे कानपुर समेत आस-पास के जिलों के मरीजों को राहत मिलेगी।
क्या होता है स्टेम सेल
स्टेम से या मूल कोशिका ऐसी कोशिकाएं होती हैं, जिनमें शरीर के किसी भी अंग को विकसित करने की क्षमता होती है। इसके साथ ही ये शरीर की दूसरी कोशिका के रूप में भी खुद को ढाल सकती हैं। डॉक्टरों के मुताबिक इन कोशिकाओं को शरीर की किसी भी कोशिका की मरम्मत के लिए प्रयोग किया जा सकता है।
11 मरीजों में परिणाम सकारात्मक
जीएसवीएम मेडिकल कॉलेज के प्राचार्य प्रो. संजय काला का कहना है कि स्टेम सेल रिसर्च यूनिट के लिए तेजी से काम किया जा रहा है। 11 मरीजों पर थेरेपी के रिजल्ट आशानुरूप मिले हैं इसलिए राज्य की पहली यूनिट के लिए आईसीएमआर की नेशनल एपेक्स कमेटी ने भी सहमति दे दी है। शासन से भी सकरात्मक परिणाम मिलने की उम्मीद है। इसके बन जाने से लाइलाज बीमारियों के साथ ही कैंसर जैसी बीमारियों पर रिसर्च का मौका भी मिलेगा।
क्या हैं स्रोत
अस्थिमज्जा, गर्भनाल का रक्त व अन्य प्रकार का रक्त स्त्रोत हैं। मां के दूध में मौजूद स्टेम कोशिकाओं को न सिर्फ स्तन कोशिकाओं बल्कि हड्डियों की कोशिकाओं, उपास्थि (कार्टिलेज), वसा, मस्तिष्क, लिवर व अग्नाशय कोशिकाओं में तब्दील किया जा सकता है।
Published on:
23 Apr 2022 06:45 pm

बड़ी खबरें
View Allकानपुर
उत्तर प्रदेश
ट्रेंडिंग
